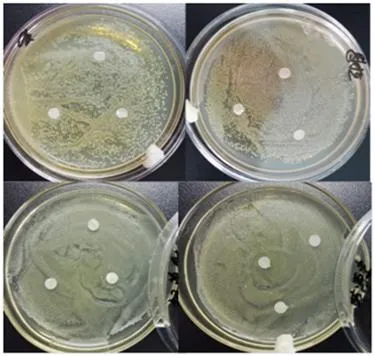
Resistance A
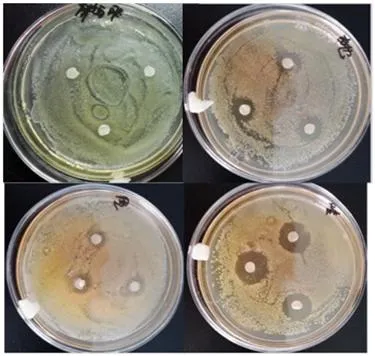
Resistance B

Clostridium butyricum is a strictly anaerobic endospore-forming Gram-positive butyric acid-producing bacillus. As a common gut commensal bacterium, it acts as a potent probiotic alternative to antibiotics for managing diarrhea, constipation, and irritable bowel syndrome. It produces short-chain fatty acids (SCFAs), primarily butyrate, which serves as energy for colonic epithelial cells and maintains gut immunological homeostasis.
Normalizes intestinal microbiota and increases Bifidobacteria and Lactobacilli abundance.
Increases butyrate in the caeca, enhancing weight gain and growth performance by 20%-30%.
Enhances immune function and reduces populations of harmful unwanted bacteria.
Suitable for: Feed Additives, Aquaculture (Shrimp/Fish), and Livestock (Broiler/Swine Farming).
Aquaculture: Mix 200g per 1 MT of feed OR 0.15 ppm for pond spray after dissolving in water.
Animal Farming: Mix 200g per 1 MT of feed OR 0.1 ppm dissolved in drinking water.
Storage: Store in a cool, dry location. Keep out of direct sunshine and moisture.

Conclusion: Clostridium acidophilus is compatible with most common antibiotics at specified dosages, including Enramycin, Nosiheptide, and Bacitracin Zinc.





| Specification | CB50 | CB100 |
|---|---|---|
| Viable count (CFU/g) | 5.0x10^9 | 1.0x10^10 |
| Color | Light yellow | Light yellow |
| Dosage | 200 g/ton | 100 g/ton |
| Parameter | Standard Limit |
|---|---|
| Loss on drying | ≤10% |
| Arsenic (As) | ≤2 mg/kg |
| Plumbum (Pb) | ≤5 mg/kg |
| Coli group | ≤100 CFU/g |
| Salmonella | Negative / 25g |
| Sample | 100g/bag, 500g/bag, 1kg/bag |
| Bulk Packaging | 20kg/25kg per drum or as requested |
| Storage Life | 24 months in cool, dry, sealed conditions |

